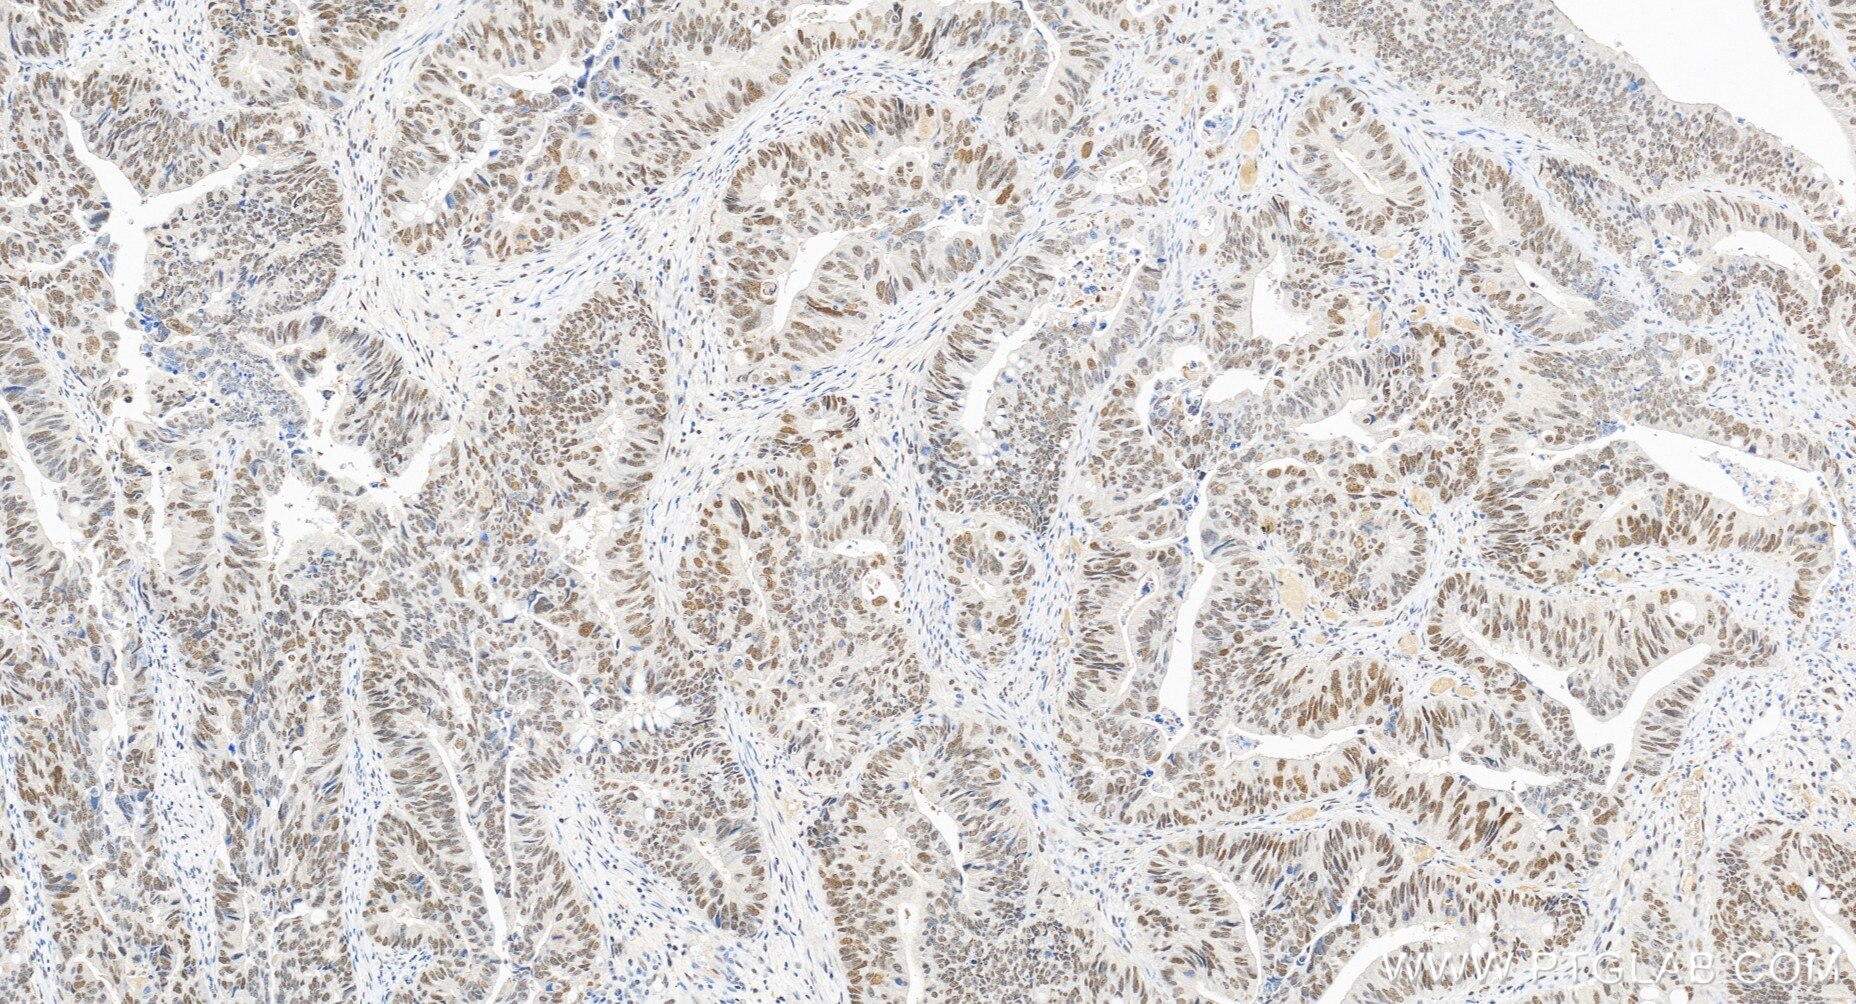
Immunohistochemistry (IHC) staining of human colon cancer tissue using PMS2 Recombinant monoclonal antibody (84894-5-RR)

Validation Data Gallery
Tested Applications
Recommended dilution
| Application | Dilution |
|---|---|
| It is recommended that this reagent should be titrated in each testing system to obtain optimal results. | |
Product Information
84894-5-PBS targets PMS2 in WB, IHC, FC (Intra), Indirect ELISA applications and shows reactivity with human samples.
| Tested Reactivity | human |
| Host / Isotype | Rabbit / IgG |
| Class | Recombinant |
| Type | Antibody |
| Immunogen |
CatNo: Ag33508 Product name: Recombinant human PMS2 protein Source: e coli.-derived, PGEX-4T Tag: GST Domain: 700-862 aa of BC093921 Sequence: QHATDEKYNFEMLQQHTVLQGQRLIAPQTLNLTAVNEAVLIENLEIFRKNGFDFVIDENAPVTERAKLISLPTSKNWTFGPQDVDELIFMLSDSPGVMCRPSRVKQMFASRACRKSVMIGTALNTSEMKKLITHMGEMDHPWNCPHGRPTMRHIANLGVISQN* 相同性解析による交差性が予測される生物種 |
| Full Name | PMS2 postmeiotic segregation increased 2 (S. cerevisiae) |
| Calculated molecular weight | 862 aa, 96 kDa |
| Observed molecular weight | 117 kDa |
| GenBank accession number | BC093921 |
| Gene Symbol | PMS2 |
| Gene ID (NCBI) | 5395 |
| Conjugate | Unconjugated |
| Form | |
| Form | Liquid |
| Purification Method | Protein A purfication |
| UNIPROT ID | P54278 |
| Storage Buffer | PBS only{{ptg:BufferTemp}}7.3 |
| Storage Conditions | Store at -80°C. |
Background Information
PMS2, also named as PMSL2, belongs to the DNA mismatch repair mutL/hexB family. It is a component of the post-replicative DNA mismatch repair system (MMR). It heterodimerizes with MLH1 to form MutL alpha. MulL alpha (MLH1-PMS2) interacts physically with the clamp loader subunits of DNA polymerase III, suggesting that it may play a role to recruit the DNA polymerase III to the site of the MMR. It also implicated in DNA damage signaling, a process which induces cell cycle arrest and can lead to apoptosis in case of major DNA damages. (PMID: 16873062, PMID: 18206974) Defects in PMS2 are the cause of hereditary non-polyposis colorectal cancer type 4 (HNPCC4). Defects in PMS2 are a cause of mismatch repair cancer syndrome (MMRCS).